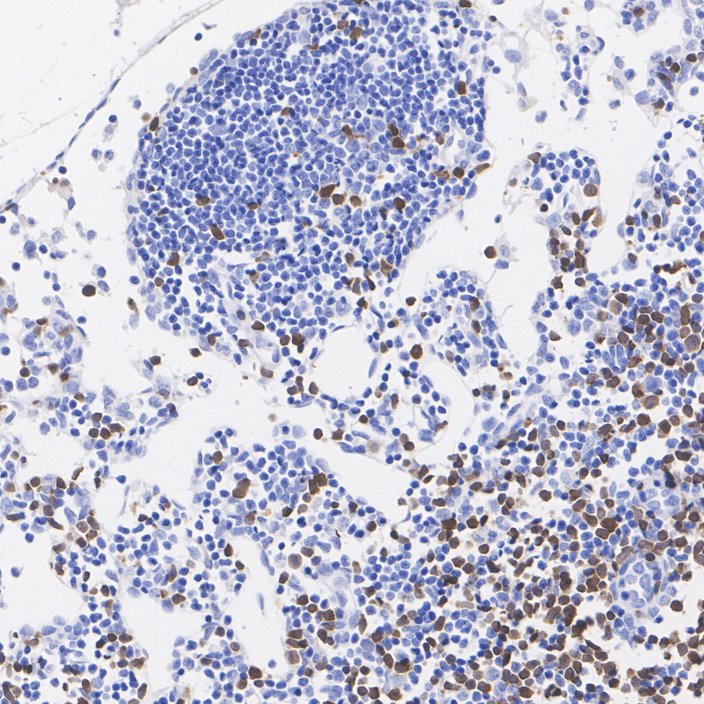

RMB: 699 特惠 1500 1500
产品规格
概述
产品名称
ZAP70 Recombinant Rabbit Monoclonal Antibody [PSH11-52]
抗体类型
Recombinant Rabbit monoclonal Antibody
免疫原
Synthetic peptide within human ZAP70 aa 301-350.
种属反应性
Human, Mouse, Rat
验证应用
WB, IF-Cell, IHC-P, FC
分子量
Predicted band size: 70 kDa
阳性对照
Jurkat cell lysate, MOLT-4 cell lysate, HUT 102 cell lysate, Jurkat, human lymph node tissue, human spleen tissue, mouse lymph node tissue, mouse spleen tissue, rat lymph node tissue, rat spleen tissue.
偶联
unconjugated
克隆号
PSH11-52
反应性数据
Tested 已验证(内部验证通过)
Published 文献已报道(未内部验证,但有文献支持)
Predicted 预测可反应(基于高同源性)
Not recommended 不推荐(内部验证未通过)
| WB | IF-Cell | IHC-P | FC | |
|---|---|---|---|---|
| Human |
|
|
|
|
| Mouse |
|
|
|
|
| Rat |
|
产品特性
形态
Liquid
浓度
存放说明
Shipped at 4℃. Store at +4℃ short term (1-2 weeks). It is recommended to aliquot into single-use upon delivery. Store at -20℃ long term.
存储缓冲液
1*PBS (pH7.4), 0.1% BSA, 40% Glycerol, 0.2% Proclean 950.
亚型
IgG
纯化方式
Protein A affinity purified.
应用稀释度
-
WB
-
1:2,000
-
IF-Cell
-
1:500
-
IHC-P
-
1:1,000
-
FC
-
1:1,000
靶点
功能
ZAP-70 (Zeta-chain-associated protein kinase 70) is a protein normally expressed near the surface membrane of lymphocytes (T cells, natural killer cells, and a subset of B cells). It is most prominently known to be recruited upon antigen binding to the T cell receptor (TCR), and it plays a critical role in T cell signaling. ZAP-70 was initially discovered in TCR-stimulated Jurkat cells, an immortal line of human T lymphocytes, in 1991. Its molecular weight is 70 kDa, and it is a member of the protein-tyrosine kinase family and is a close homolog of SYK. SYK and ZAP70 share a common evolutionary origin and split from a common ancestor in the jawed vertebrates. The importance of ZAP-70 in T cell activation was determined when comparing ZAP-70 expression in patients with SCID (severe combined immunodeficiency). ZAP-70 deficient individuals were found to have no functioning T cells in their peripheral blood, suggesting that ZAP-70 is a critical component of T cell activation and development. ZAP-70 expression in B cells is correlated with the development of chronic lymphocytic leukemia (CLL).
背景文献
1. Ashouri JF et al. ZAP70, too little, too much can lead to autoimmunity. Immunol Rev. 2022 May
2. Leveille E et al. SYK and ZAP70 kinases in autoimmunity and lymphoid malignancies. Cell Signal. 2022 Jun
亚细胞定位
Cytoplasm. Cell membrane.
别名
70 kDa zeta associated protein antibody
70 kDa zeta-associated protein antibody
EC 2.7.10.2 antibody
FLJ17670 antibody
FLJ17679 antibody
Selective T cell defect antibody
SRK antibody
STD antibody
Syk related tyrosine kinase antibody
Syk-related tyrosine kinase antibody
展开70 kDa zeta associated protein antibody
70 kDa zeta-associated protein antibody
EC 2.7.10.2 antibody
FLJ17670 antibody
FLJ17679 antibody
Selective T cell defect antibody
SRK antibody
STD antibody
Syk related tyrosine kinase antibody
Syk-related tyrosine kinase antibody
Truncated ZAP kinase antibody
Tyrosine protein kinase ZAP70 antibody
Tyrosine-protein kinase ZAP-70 antibody
TZK antibody
ZAP 70 antibody
ZAP70 antibody
ZAP70_HUMAN antibody
Zeta chain associated protein kinase 70kD antibody
Zeta chain associated protein kinase 70kDa antibody
Zeta chain associated protein kinase 70kDa isoform 1 antibody
Zeta chain associated protein kinase 70kDa isoform 2 antibody
Zeta chain of T cell receptor associated protein kinase 70 antibody
Zeta chain TCR associated protein kinase 70kD antibody
Zeta chain TCR associated protein kinase 70kDa antibody
折叠图片
-

☑ Relative expression (RE)
Western blot analysis of ZAP70 on different lysates with Rabbit anti-ZAP70 antibody (HA723344) at 1/2,000 dilution.
Lane 1: Jurkat cell lysate
Lane 2: Ramos cell lysate (negative)
Lane 3: MOLT-4 cell lysate
Lane 4: Raji cell lysate (negative)
Lane 5: HUT 102 cell lysate
Lysates/proteins at 20 µg/Lane.
Predicted band size: 70 kDa
Observed band size: 70 kDa
Exposure time: 6 seconds; ECL: K1801;
4-20% SDS-PAGE gel.
Proteins were transferred to a PVDF membrane and blocked with 5% NFDM/TBST for 1 hour at room temperature. The primary antibody (HA723344) at 1/2,000 dilution was used in 5% NFDM/TBST at 4℃ overnight. Goat Anti-Rabbit IgG - HRP Secondary Antibody (HA1001) at 1/50,000 dilution was used for 1 hour at room temperature. -

☑ Relative expression (RE)
Immunocytochemistry analysis of Jurkat (positive) and Ramos (negative) labeling ZAP70 with Rabbit anti-ZAP70 antibody (HA723344) at 1/500 dilution.
Cells were fixed in 4% paraformaldehyde for 15 minutes at room temperature, permeabilized with 0.1% Triton X-100 in PBS for 15 minutes at room temperature, then blocked with 1% BSA in 10% negative goat serum for 1 hour at room temperature. Cells were then incubated with Rabbit anti-ZAP70 antibody (HA723344) at 1/500 dilution in 1% BSA in PBST overnight at 4 ℃. Goat Anti-Rabbit IgG H&L (iFluor™ 488, HA1121) was used as the secondary antibody at 1/1,000 dilution. PBS instead of the primary antibody was used as the secondary antibody only control. Nuclear DNA was labelled in blue with DAPI.
Beta tubulin (HA601187, red) was stained at 1/100 dilution overnight at +4℃. Goat Anti-Mouse IgG H&L (iFluor™ 594, HA1126) was used as the secondary antibody at 1/1,000 dilution. -

Immunohistochemical analysis of paraffin-embedded human lymph node tissue with Rabbit anti-ZAP70 antibody (HA723344) at 1/1,000 dilution.
The section was pre-treated using heat mediated antigen retrieval with Tris-EDTA buffer (pH 9.0) for 20 minutes. The tissues were blocked in 1% BSA for 20 minutes at room temperature, washed with ddH2O and PBS, and then probed with the primary antibody (HA723344) at 1/1,000 dilution for 1 hour at room temperature. The detection was performed using an HRP conjugated compact polymer system. DAB was used as the chromogen. Tissues were counterstained with hematoxylin and mounted with DPX. -

Immunohistochemical analysis of paraffin-embedded human spleen tissue with Rabbit anti-ZAP70 antibody (HA723344) at 1/1,000 dilution.
The section was pre-treated using heat mediated antigen retrieval with Tris-EDTA buffer (pH 9.0) for 20 minutes. The tissues were blocked in 1% BSA for 20 minutes at room temperature, washed with ddH2O and PBS, and then probed with the primary antibody (HA723344) at 1/1,000 dilution for 1 hour at room temperature. The detection was performed using an HRP conjugated compact polymer system. DAB was used as the chromogen. Tissues were counterstained with hematoxylin and mounted with DPX. -

☑ Relative expression (RE)
Immunohistochemical analysis of paraffin-embedded human liver tissue (negative) with Rabbit anti-ZAP70 antibody (HA723344) at 1/1,000 dilution.
The section was pre-treated using heat mediated antigen retrieval with Tris-EDTA buffer (pH 9.0) for 20 minutes. The tissues were blocked in 1% BSA for 20 minutes at room temperature, washed with ddH2O and PBS, and then probed with the primary antibody (HA723344) at 1/1,000 dilution for 1 hour at room temperature. The detection was performed using an HRP conjugated compact polymer system. DAB was used as the chromogen. Tissues were counterstained with hematoxylin and mounted with DPX. -
Immunohistochemical analysis of paraffin-embedded mouse lymph node tissue with Rabbit anti-ZAP70 antibody (HA723344) at 1/1,000 dilution.
The section was pre-treated using heat mediated antigen retrieval with Tris-EDTA buffer (pH 9.0) for 20 minutes. The tissues were blocked in 1% BSA for 20 minutes at room temperature, washed with ddH2O and PBS, and then probed with the primary antibody (HA723344) at 1/1,000 dilution for 1 hour at room temperature. The detection was performed using an HRP conjugated compact polymer system. DAB was used as the chromogen. Tissues were counterstained with hematoxylin and mounted with DPX. -

Immunohistochemical analysis of paraffin-embedded mouse spleen tissue with Rabbit anti-ZAP70 antibody (HA723344) at 1/1,000 dilution.
The section was pre-treated using heat mediated antigen retrieval with Tris-EDTA buffer (pH 9.0) for 20 minutes. The tissues were blocked in 1% BSA for 20 minutes at room temperature, washed with ddH2O and PBS, and then probed with the primary antibody (HA723344) at 1/1,000 dilution for 1 hour at room temperature. The detection was performed using an HRP conjugated compact polymer system. DAB was used as the chromogen. Tissues were counterstained with hematoxylin and mounted with DPX. -

☑ Relative expression (RE)
Immunohistochemical analysis of paraffin-embedded mouse liver tissue (negative) with Rabbit anti-ZAP70 antibody (HA723344) at 1/1,000 dilution.
The section was pre-treated using heat mediated antigen retrieval with Tris-EDTA buffer (pH 9.0) for 20 minutes. The tissues were blocked in 1% BSA for 20 minutes at room temperature, washed with ddH2O and PBS, and then probed with the primary antibody (HA723344) at 1/1,000 dilution for 1 hour at room temperature. The detection was performed using an HRP conjugated compact polymer system. DAB was used as the chromogen. Tissues were counterstained with hematoxylin and mounted with DPX. -

Immunohistochemical analysis of paraffin-embedded rat lymph node tissue with Rabbit anti-ZAP70 antibody (HA723344) at 1/1,000 dilution.
The section was pre-treated using heat mediated antigen retrieval with Tris-EDTA buffer (pH 9.0) for 20 minutes. The tissues were blocked in 1% BSA for 20 minutes at room temperature, washed with ddH2O and PBS, and then probed with the primary antibody (HA723344) at 1/1,000 dilution for 1 hour at room temperature. The detection was performed using an HRP conjugated compact polymer system. DAB was used as the chromogen. Tissues were counterstained with hematoxylin and mounted with DPX. -

Immunohistochemical analysis of paraffin-embedded rat spleen tissue with Rabbit anti-ZAP70 antibody (HA723344) at 1/1,000 dilution.
The section was pre-treated using heat mediated antigen retrieval with Tris-EDTA buffer (pH 9.0) for 20 minutes. The tissues were blocked in 1% BSA for 20 minutes at room temperature, washed with ddH2O and PBS, and then probed with the primary antibody (HA723344) at 1/1,000 dilution for 1 hour at room temperature. The detection was performed using an HRP conjugated compact polymer system. DAB was used as the chromogen. Tissues were counterstained with hematoxylin and mounted with DPX. -

☑ Relative expression (RE)
Immunohistochemical analysis of paraffin-embedded rat liver tissue (negative) with Rabbit anti-ZAP70 antibody (HA723344) at 1/1,000 dilution.
The section was pre-treated using heat mediated antigen retrieval with Tris-EDTA buffer (pH 9.0) for 20 minutes. The tissues were blocked in 1% BSA for 20 minutes at room temperature, washed with ddH2O and PBS, and then probed with the primary antibody (HA723344) at 1/1,000 dilution for 1 hour at room temperature. The detection was performed using an HRP conjugated compact polymer system. DAB was used as the chromogen. Tissues were counterstained with hematoxylin and mounted with DPX. -

☑ Relative expression (RE)
Flow cytometric analysis of Ramos (left, negative) and Jurkat (right, positive) cells labeling ZAP70.
Cells were fixed and permeabilized. Then stained with the primary antibody (HA723344, 1/1,000) (red) compared with Rabbit IgG Isotype Control (green). After incubation of the primary antibody at +4℃ for an hour, the cells were stained with a iFluor™ 488 conjugate-Goat anti-Rabbit IgG Secondary antibody (HA1121) at 1/1,000 dilution for 30 minutes at +4℃. Unlabelled sample was used as a control (cells without incubation with primary antibody; black).
请注意: All products are "FOR RESEARCH USE ONLY AND ARE NOT INTENDED FOR DIAGNOSTIC OR THERAPEUTIC USE"
同靶点 & 同通路的产品
ZAP70 Mouse Monoclonal Antibody [A1B5]
Application: WB,IHC-P,FC,IF-Cell
Reactivity: Human,Mouse,Rat
Conjugate: unconjugated
ZAP70 Recombinant Rabbit Monoclonal Antibody [JU08-39]
Application: WB,IF-Cell,IHC-P,FC,IP
Reactivity: Human
Conjugate: unconjugated
ZAP70 Recombinant Mouse Monoclonal Antibody [A1B5-R]
Application: WB,IHC-P
Reactivity: Human,Mouse,Rat
Conjugate: unconjugated
ZAP70 Recombinant Mouse Monoclonal Antibody [A1B5-R] - BSA and Azide free
Application: WB,IHC-P
Reactivity: Human,Mouse,Rat
Conjugate: unconjugated
ZAP70 Mouse Monoclonal Antibody [A1B7]
Application: WB,IF-Cell,FC
Reactivity: Human,Mouse,Rat
Conjugate: unconjugated










 浙公网安备 33019202000643号
浙公网安备 33019202000643号